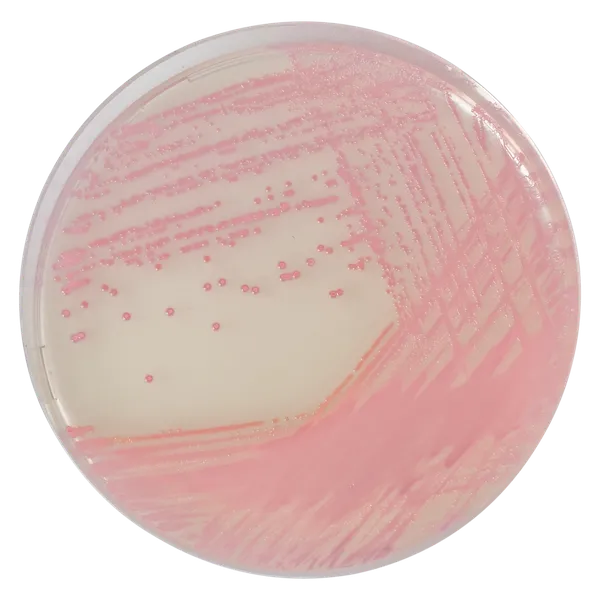
CHROMagar™ MRSA

Hình thái khuẩn lạc
Hiệu năng
Hiệu năng
Nguyên nhân chính gây nhiễm khuẩn bệnh viện, đặc biệt trong các đơn vị chăm sóc đặc biệt, nguồn MRSA có thể là nội sinh (bệnh nhân) hoặc qua lây nhiễm chéo (môi trường hoặc qua tiếp xúc cá nhân). Vấn đề lớn với tác nhân gây bệnh này là khả năng kháng với một loạt kháng sinh, trong đó có kháng sinh beta-lactam, làm hạn chế các lựa chọn điều trị cho bác sĩ.
Phát hiện sớm là cần thiết để kiểm soát sự lây lan của MRSA, cung cấp chăm sóc phù hợp và tránh các điều trị phức tạp và tốn kém. Kiểm tra sàng lọc trước khi nhập viện đối với MRSA đã chứng minh là phương pháp hiệu quả để giảm gánh nặng bệnh MRSA trong bệnh viện. Tiết kiệm do khử trùng đồng bộ trước khi nhập viện lớn hơn chi phí sàng lọc. Hiện nay, ở Mỹ, chi phí thêm liên quan đến điều trị khó khăn các nhiễm trùng MRSA ước tính là 2,4 tỷ USD cho khoảng 370,000 lần nằm viện. (Genetic Engineering and Biotechnology News, August 2009).
Ở Anh, ước tính chi phí bổ sung khi xuất viện cho mỗi bệnh nhân mắc MRSA là £9,000.
Mục đích sử dụng :
CHROMagar™ MRSA là môi trường chromogen chọn lọc và phân biệt để phát hiện định tính trực tiếp tình trạng mang mầm bệnh kháng methicillin Staphylococcus aureus (MRSA) nhằm hỗ trợ ngăn ngừa và kiểm soát MRSA trong các cơ sở y tế. Xét nghiệm được thực hiện trên mẫu gạc mũi trước hoặc quanh hậu môn từ bệnh nhân và nhân viên y tế để sàng lọc tình trạng mang mầm bệnh MRSA. Kết quả có thể được diễn giải sau 18-24 giờ ủ hiếu khí ở 35-37 °C.
CHROMagar™ MRSA không dùng để chẩn đoán, hướng dẫn hay theo dõi liệu pháp cho các nhiễm trùng MRSA, cũng như không cung cấp kết quả độ nhạy với methicillin. Thiếu sự tăng trưởng hoặc không có khuẩn lạc màu hồng trên CHROMagar™ MRSA không loại trừ sự hiện diện của MRSA. Cần thực hiện xác định thêm, xét nghiệm độ nhạy và phân loại dịch tễ học trên các khuẩn lạc nghi ngờ.
CHROMagar™ MRSA cũng có thể được sử dụng kết hợp với các xét nghiệm phòng thí nghiệm khác và dữ liệu lâm sàng để hỗ trợ nhận diện và chẩn đoán các nhiễm trùng MRSA trên da, mô mềm, vết thương và nuôi cấy máu dương tính. Cần các nuôi cấy đồng thời để thu hồi vi sinh vật cho xét nghiệm độ nhạy vi sinh hoặc phân loại dịch tễ học thêm.
1. Hoàn toàn tin cậy: CHROMagar™ MRSA, được giới thiệu năm 2002, là môi trường chromogen đầu tiên để phát hiện MRSA. Nó đã dẫn đến giảm đáng kể cả thời gian phản hồi và khối lượng công việc phòng thí nghiệm, cho phép sàng lọc bệnh nhân trên quy mô lớn cần thiết.
2. Hiệu quả: Môi trường cho thấy giá trị độ nhạy và đặc hiệu gần 100%. CHROMagar™ MRSA cho phép phát hiện chính xác MRSA với mức độ nhạy cao hơn so với môi trường chứa oxacillin.
3. Nhanh chóng & dễ diễn giải: Màu khuẩn lạc tím nhạt đặc trưng trong 18-24 giờ.
 <img src="/Data-EN-8-1754044329.png" width="1024" height="574" alt="" title="Data EN" />
<img src="/Data-EN-8-1754044329.png" width="1024" height="574" alt="" title="Data EN" />
Thành phần
 <img class="vce-single-image" src="https://media.loveitopcdn.com/42972/Composition-EN-1-1754044332-1772078184.png" width="780" height="475" alt="" title="Composition EN" />
<img class="vce-single-image" src="https://media.loveitopcdn.com/42972/Composition-EN-1-1754044332-1772078184.png" width="780" height="475" alt="" title="Composition EN" /> Tài liệu kỹ thuật
Công bố khoa học
2023
Methicillin-resistant Staphyloccocus spp. Colonization among pregnant women considering different scenarios related to Covid-19 pandemic in Brazil
? Publication2023
Detection of Methicillin Resistant Staphylococcus aureus (MRSA) by CHROMagar Versus Cefoxitin Disk Diffusion Method
? Publication2022
Methicillin-resistant Staphylococcus spp. colonization among pregnant women considering scenarios before and after the onset of COVID-19 pandemic in Rio de Janeiro, Brazil
? Publication2022
Multidrug resistant bacteria on air, inanimate surface and medical equipment in an intensive care unit in Lima, Peru
? Publication2018
Media Makes a Difference in the Detection of Surveillance Isolates of Methicillin Resistant Staphylococcus aureus using the Bruker MALDI-TOF Mass Spectrometry MRSA PSM-mec Detection Module
? Publication2017
Implementation of Colorex MRSA/VRE bi-plate on WASP/WASPLab to screen for MRSA and VRE using Eswab duo swab
? Publication2016
Evaluation of Different Phenotypic and Genotypic Methods for Detection of Methicillin Resistant Staphylococcus aureus (MRSA)
? Publication2015
Screening agars for MRSA: evaluation of a stepwise diagnostic approach with two different selective agars for the screening for methicillin-resistant Staphylococcus aureus (MRSA)
? Publication2014
Detection of Staphylococcus Aureus and Methicillinresistant Staphylococcus Aureus (MRSA) from human clinical specimens using conventional biochemical tests and Chromogenic media
? Publication2012
Performance of CHROMagar Staph aureus and CHROMagar MRSA for Detection of Airborne Methicillin-Resistant and Methicillin-Sensitive Staphylococcus aureus DOI: 10.1080/02786826.2011.626001
? Publication2012
A multi-beach study of Staphycoloccus aureus, MRSA, and enterococci in seawater and beach sand
? Publication2011
Evaluation of a new CHROMagar Medium for Detection of Methicillin Resistant Staphylococcus aureus
? Publication2006
Evaluation of a new chromogenic medium for isolation and presumptive identification of methicillin-resitant Staphylococcus aureus from human clinical specimens
? Publication2005
Performance of CHROMagar MRSA medium for detection of Methicillin-Resitant Staphylococcus aureus.
? Publication2005
Evaluation of CHROMagar MRSA for detection of Methicillin-resistant Staphylococcus aureus.
? Publication2005
Evaluation of new CHROMagar MRSA to detection of MRSA from the clinical specimens. (Heavy file > 6,2 Mbytes)
? Publication

Xem thêm